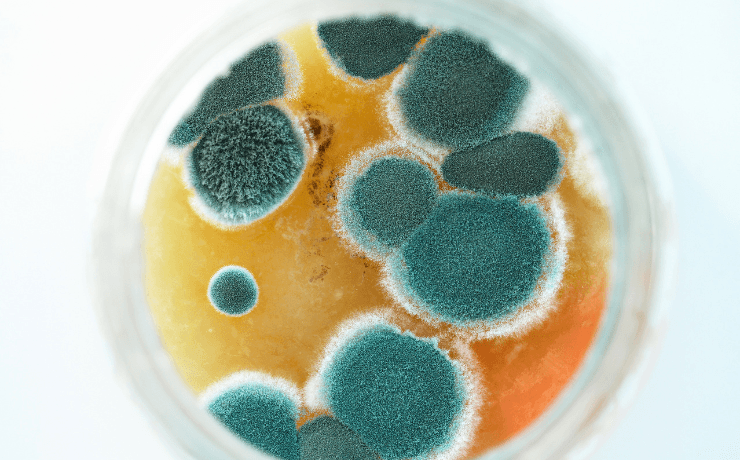

Je bent verslaafd aan koffie. Time to wake up!
Waarom die “onschuldige” kop koffie je energie saboteert, je hormonen in de war brengt en je langzaam kapot maakt
Ik weet dat je dit niet wilt horen. Die koffie die je elke ochtend als een reddingsboei vastgrijpt? Die warme troost die je door je dag sleept? Die sociale glue van al je meetings?
Het is een drug. En jij bent verslaafd.
“Maar Tanja, iedereen drinkt koffie! Het kan toch niet zo erg zijn?” Oh sweet summer child, iedereen rookte ook ooit. Iedereen dacht dat vet dik maakte. Iedereen geloofde dat de aarde plat was. Populariteit is geen bewijs van waarheid. Laat me je ogen openen voor wat koffie ECHT met je doet. Spoiler alert: het is niet mooi en je kan dit hierna niet meer niet-weten.
De harde wetenschap: waarom koffie je vijand is
1. De Adenosine-hijack: je natuurlijke energiesysteem wordt gekaapt
Adenosine is je lichaam’s natuurlijke “moeheid-detector.” Het bouwt zich op in je hersenen tijdens de dag en als er genoeg is, krijg je het signaal: tijd om te rusten. Pure biologie, perfect systeem.
Cafeïne? Dat blokkeert je adenosine-receptoren. Het is alsof je de brandmelder in je huis afplakt – je ruikt de rook niet meer, maar het huis staat nog steeds in brand.
Je lichaam denkt: “Hmm, ik krijg geen moeheid-signalen meer binnen. Ik moet meer adenosine-receptoren maken!” En dat doet het. Steeds meer. Resultaat? Tolerance. Je hebt steeds meer koffie nodig voor hetzelfde effect.
En als die cafeïne uitgewerkt is? Al die opgehoopte adenosine overspoelt je systeem als een tsunami. Hello crash. 🥱 Dag energie. Hoi snoeptrek. 🐷
De research: Studies tonen aan dat chronische cafeïne-gebruikers 40% meer adenosine-receptoren hebben dan niet-gebruikers. Je hebt letterlijk je brein geherprogrammeerd om afhankelijk te zijn van een externe drug.
2. Cortisol chaos: je stresshormoon gaat door het dak
Herinner je je mijn eerdere research over cortisol en gewichtstoename? Nou, jouw dagelijkse koffie is een cortisol-trigger van formaat.
De wetenschappelijke feiten:
- Cafeïne verhoogt cortisol-niveaus met 30-50% binnen 30 minuten
- Dit effect houdt 6-8 uur aan (ja, die ochtendkoffie saboteert nog steeds je systeem als je gaat lunchen)
- Bij gestressde mensen wordt dit effect nog erger – cortisol gaat door het dak
- Chronisch verhoogde cortisol = buikvet, slaapproblemen, diabetes-risico
De vicieuze cirkel: Stress → koffie voor energie → meer stress door verhoogde cortisol → meer koffie nodig → nog meer stress. See the pattern?
3. Slaap sabotage: waarom je ’s nachts ligt te woelen
Cafeïne heeft een halfwaardetijd van 5-6 uur. Dat betekent:
- Koffie om 08:00? Om 14:00 nog 50% actief
- Koffie om 15:00? Om 21:00 nog 50% actief
- En om 03:00 ’s nachts? Nog steeds 25% van die middagkoffie in je systeem
De research is glashelder: Cafeïne verkort je diepe slaapfases met 25-40%. Je slaapt misschien, maar je herstelt niet. Je wordt wakker als een slaapwandelaar en grijpt naar… koffie. 😝
Het resultaat volgens de wetenschap:
- Minder dan 6 uur slaap = 40% slechtere insulinegevoeligheid de volgende dag
- Slaapgebrek verhoogt ghreline (hongerhormoon) en verlaagt leptine (verzadigingshormoon)
- Kans op diabetes type 2 stijgt met 30% bij chronisch slaapgebrek
Koffie → slechte slaap → hormoon chaos → diabetes-risico. De cirkel is rond.
4. De mineralen-roof: koffie steelt je gezondheid
Hier wordt het pas echt crimineel. Koffie is een mineralendief van de bovenste plank:
Calcium-sabotage: Koffie vermindert calcium-opname. Elke kop koffie = calcium verlies. Drink je 3 koppen per dag? Dan verlies je jaarlijks genoeg calcium voor merkbare botdichtheid-afname.
IJzer-blokkade: Koffie remt ijzeropname als je het binnen 1 uur van een maaltijd drinkt. Vermoeid? Misschien niet omdat je koffie tekort komt, maar omdat je ijzer tekort hebt.
Magnesium-exodus: Koffie stimuleert magnesium-verlies via de nieren. Magnesium-tekort = spierkrampen, hoofdpijn, slapeloosheid, angst, hartkloppingen. Klinkt bekend?
Zink en andere spoorelementen: Koffie kan de opname van verschillende mineralen verstoren, waardoor tekorten kunnen ontstaan die je immuunsysteem, hormoonbalans en wondgenezing kunnen beïnvloeden.
B-vitamine blocking: Vooral B1 (thiamine) wordt slecht opgenomen. B1 is essentieel voor energiemetabolisme. Ironisch, toch? Je drinkt koffie voor energie, maar het blokkeert de vitamines die je échte energie geven.
5. Neurotransmitter-chaos: je brein wordt gehijacked
Koffie ontwricht je hele breinchemie:
Noradrenaline-overdosis: Koffie zorgt voor chronisch verhoogde noradrenaline. Dat is je fight-or-flight hormoon. Je zit de hele dag in survival-modus. Rust? Welke rust? Je lichaam denkt constant dat er gevaar is, waardoor je stress-reacties op overdrive staan. Zelfs kleine frustraties voelen plots als existentiële crises.
Dopamine-desensitizing: Je brein wordt minder gevoelig voor dopamine (je beloningshormoon). Resultaat? Minder plezier uit normale dingen. Je hebt steeds meer stimulatie nodig om je goed te voelen. Die mooie zonsondergang die je vroeger kon waarderen? Meh. Die leuke film? Saai. Je brein schreeuwt om meer, meer, meer – en koffie lijkt tijdelijk de oplossing.
GABA-suppressie: GABA is je natuurlijke chill-pill. Koffie onderdrukt het. Geen wonder dat je ’s avonds niet kunt ontspannen. Je lichaam heeft letterlijk minder van het ‘rem-neurotransmitter’ dat je kalm zou moeten houden. Het is alsof je auto alleen een gaspedaal heeft, geen rem.
Serotonine-chaos: Verstoring van je gelukshormoon. Hello mood swings, irritabiliteit, en die famous “bitch-modus” voor je eerste koffie. Je baseline geluk daalt, waardoor je afhankelijk wordt van externe triggers voor een goed gevoel. Zonder koffie ben je letterlijk een minder gelukkige versie van jezelf.
Plot twist: waarom “decaf” ook bullshit is
Decaf bevat nog steeds cafeïne: Tot 7mg per kop. Klinkt weinig, maar bij gevoelige mensen of meerdere koppen per dag tikt het aan. Voor context: gevoelige mensen merken al effecten vanaf 12-25mg cafeïne. Drink je 3 koppen decaf? Dan zit je al op het niveau van een zwakke groene thee.
Chemische processing hell: De meeste decaf wordt gemaakt met methyleenchloride of ethylacetaat. Carcinogene stoffen die je lever moet detoxen. Je vervangt één toxine door een andere. Er bestaan wel “water-processed” decaf varianten, maar die zijn duurder en veel moeilijker te vinden. Plus, je lost hiermee nog steeds niet de andere problemen op.
Aciditeit-probleem: Koffie is zuur (pH 4.5-5). Dat verstoort je maag-darmstelsel, stimuleert cortisol-productie via stress op je bijnieren, en kan gastritis veroorzaken. Decaf is vaak nog zuurder dan gewone koffie door het verwerkingsproces. Herken je dat brandende gevoel, opboeren of maagpijn na koffie? Dat is je maag die schreeuwt om hulp – de zuurgraad irriteert je maagslijmvlies en kan leiden tot ontstekingen.
Mycotoxines: En hier wordt het pas echt vervelend – dit probleem geldt voor ALLE koffie, ook die dure specialty blends. Schimmeltoxines ontstaan tijdens het drogen en opslaan van koffiebonen, vooral in tropische klimaten waar vochtigheid hoog is. Studies tonen aan dat 91.7% van groene koffiebonen en 100% van commerciële instant koffie mycotoxines bevatten. Deze toxines (vooral ochratoxine A en aflatoxines) belasten je lever, kunnen ontstekingsreacties triggeren en worden gelinkt aan nierschade.
Mijn eigen koffie-detox journey (het was niet makkelijk)
Laat ik eerlijk zijn: ik was ook verslaafd. Hardcore. 4-5 koppen per dag, vanaf mijn 16e. Ik dacht dat ik zonder koffie zou sterven. Letterlijk. ☕️💀
Fase 1: Ontkenning (maanden 1-6) 🙈 “Ik drink alleen biologische koffie, dat is anders.” “Ik heb geen problemen, ik functioneer prima.” “Iedereen drinkt koffie, dus het kan niet slecht zijn.”
Classic addict behavior. Check. ✅
Fase 2: Halve maatregelen (maanden 6-12) 😅 Overstap naar “cafeïnevrije” koffie. Voelde me superieur. Tot ik de research deed over die chemische processing en resttoxines. Shit. 💩
Fase 3: Zwarte thee transitie (maanden 12-18) 🍃 Thee heeft minder cafeïne (25-50mg vs 100-200mg in koffie). Met melk voelde het nog “normaal.” Maar alsnog cafeïne, alsnog afhankelijkheid, alsnog cortisol-spikes. 📈
Fase 4: Cold turkey (maand 18-19) 😵💫 Holy shit. De eerste week was hell. Hoofdpijn die voelde alsof mijn schedel zou exploderen. 🤯 Moeheid alsof ik griep had. Mood swings die mijn familie deden twijfelen aan mijn geestelijke gezondheid. 😤
Maar toen… magie. ✨
Week 3-4: De doorbraak 🌅 Ineens werd ik wakker en was ik… wakker. Zonder externe drug. Mijn natuurlijke circadiaan ritme kwam terug. Die 15:00 crash? Verdwenen. Poof! 💫
Maand 2-3: Het nieuwe normaal 🦋 Stabiele energie de hele dag. Diepe slaap (eindelijk!). 😴 Minder stress-reacties. Mijn mood was stabiel – geen meer van die jekyll-and-hyde shit. 😇
Nu, 2 jaar later: 🏆 Eén kopje zwarte thee in de ochtend, max. En zelfs dat overweeg ik nog te droppen. Want ik merk het verschil op dagen dat ik het niet drink: nóg stabieler, nóg rustiger. 🧘♀️
Mijn huidige energie-protocol
In plaats van koffie als valse energiebooster, doe ik dit:
Ochtend-ritual (07:00-09:00) 🌄
Mijn dag begint met een MetaPWR Advantage shot – pure plant-power zonder crash, gewoon clean focus. Daarbij neem ik 2 capsules Mito2Max die mijn mitochondriën (cellulaire energiefabrieken) ondersteunen op natuurlijke wijze en 2 MetaPWR softgels voor gezonde vetverbranding. En ja, ik drink nog één kopje zwarte thee (met 1/2 theezakje) – mijn laatste restje cafeïne-ritueel waar ik aan werk! 🍵
Als ik toch een dipje ervaar 🔋
In plaats van naar die tweede koffie te grijpen, neem ik overdag nog 2 Mito2Max capsules voor sustainable energy zonder crash. Maar meestal ga ik 10 minuten wandelen om mijn natuurlijke energy systems te activeren, spring 5 minuten op mijn trampoline (staat bij mij in de woonkamer), dans door mijn keuken of ik neem een 30 seconden koude douche voor instant alertness via een natural noradrenaline boost! 🚿❄️
De échte energy-game changers zijn veel simpeler dan je denkt:
Hier is de waarheid die de koffie-industrie je niet wil vertellen. Echte energie komt van gebalanceerd eten voor stabiele bloedsuiker (geen achtbaan = geen crashes), voldoende beweging in de zon en natuur waarbij bomen en planten volatile organic compounds produceren die je stresshormonen verlagen en je immuunsysteem boosten. Zonlicht triggert niet alleen vitamine D-productie, maar optimaliseert ook je circadiaan ritme via je pijnappelklier, wat je natuurlijke melatonine-productie reguleert. De hogere zuurstofconcentratie in natuurgebieden verbetert je cellulaire energieproductie, terwijl natuurlijke geluiden je stress-respons downreguleren. Dan heb je nog activiteiten met fijne mensen die je blij maken (joy is letterlijk een natuurlijke energizer), en emotionele balans omdat stress energie vreet terwijl inner peace energie geeft. Plus natuurlijk die 7-9 uur kwaliteitsslaap die je next-day superpowers geeft. No drugs needed.
Het koffie-afkick-protocol dat werkt
Want ik weet dat je nu denkt: “Oké Tanja, I get it, maar HOE stop ik zonder te sterven?”
Optie 1: Cold Turkey (voor rebellen) 🔥
Stop vandaag, completely. Expect hell voor 7-10 dagen, dan paradise. Je survival kit: veel water omdat je lichaam nu in detox-modus gaat en extra hydratatie nodig heeft om alle opgehoopte toxines uit te spoelen via nieren en lever, doTERRA Zendocrine Complex voor extra nierondersteuning tijdens de detox, doTERRA Bone Nutrient (magnesium-supplement) voor ontspannen spieren (je kan ongemak in je spieren verwachten tijdens je koffie detox) , Mito2Max voor energie-ondersteuning op cellulair niveau, peppermint olie of doTERRA PastTense op je slapen en nek voor natuurlijke verlichting bij hoofdspanning (werkt beter dan pillen en beschadigt je microbioom niet!), en waarschuw collega’s, familie en vrienden dat je tijdelijk niet zo leuk gaat zijn! 😂
Optie 2: Geleidelijk Afbouwen (voor normaal stervelingen) 🐌
Week 1-2 halveer je koffie-intake, week 3-4 switch naar zwarte thee, week 5-6 halveer je thee-intake, week 7-8 alleen nog één kopje thee plus kruidenthee, week 9-10 alleen kruidenthee, en vanaf week 11 ben je een free bird! 🕊️
Natuurlijke energie alternatieven tijdens je detox zijn doTERRA Mito2Max voor cellulaire energieproductie, doTERRA MetaPWR Advantage voor stabiele energie zonder crash, doTERRA MetaPWR Recharge voor essentiële mineralen die je lichaam nodig heeft tijdens het herstel, doTERRA Copaiba softgels voor natuurlijke ontstekingsbalans en stress-ondersteuning, doTERRA Serenity Restful Complex met tart cherry voor betere slaapkwaliteit en probeer ook eens groene thee matcha voor minder cafeïne maar meer L-theanine (calm alertness).
What to expect: de koffie-detox timeline
De eerste 3 dagen zijn The Withdrawal Hell met hoofdpijn, moeheid, irritabiliteit en brain fog – je lichaam gilt om zijn drug, maar stay strong! 💪 Dag 4-7 begint de nevel op te trekken, hoofdpijn vermindert en je krijgt glimpses van je natuurlijke energie. Week 2 brengt voorzichtige optimism omdat je energie stabieler wordt, slaap verbetert en stemming stabiliseert.
Week 3-4 is waar de magie begint – holy shit, je wordt wakker en bent gewoon wakker zonder extra’s needed, dit is hoe normaal voelt! 🤯 Maand 2-3 ervaar je stabiele energie, diepe slaap, balanced mood en minder stress-reacties – you never want to go back. En na maand 6 kijk je naar koffiedrinkers zoals ex-rokers naar rokers kijken: met medelijden en begrip. 😌
Maar Tanja, wat als ik toch koffie wil blijven drinken?”
Kijk, ik ben je moeder niet. Maar als je per se koffie wilt blijven drinken, hier is je damage control: max 1 kopje per dag vóór 10:00, altijd met eten om de impact te bufferen, hoogwaardige bonen voor minder mycotoxines, extra magnesium en vitamines supplementeren, en geen koffie 2 uur voor en na maaltijden vanwege ijzeropname. Neem daarnaast elke 3-4 weken een week pauze om je tolerance te resetten en je bijnieren rust te geven.
De inconvenient truth
Hier is wat niemand je vertelt over koffie: het is sociale conditioning. Die hele “maar ik kan niet zonder koffie”-cultuur is marketing, peer pressure en collective addiction normalization. Het maskeert onderliggende problemen – ben je moe? Fix dan je slaap, voeding en stress in plaats van symptomen maskeren met een drug. En het houdt je klein omdat natural energy altijd beter is dan artificial energy. Je verdient beter dan afhankelijk zijn van een external substance.
Your move
Je hebt nu de feiten, de science, de waarheid. Je kunt dit blijven wegrationaliseren met “iedereen doet het,” “een beetje kan geen kwaad,” of “ik heb het nodig voor mijn werk.” Of je accepteert de inconvenient truth en onderneemt actie.
Option 1: Blijf slaafs aan je koffie en accepteer de energy crashes, slaapproblemen, mineraal-deficiënties en hormonale chaos als “normaal.”
Option 2: Take back control, detox je systeem, ontdek je natuurlijke energie en word de persoon die je kunt zijn zonder chemische afhankelijkheid.
Dus…Wat wordt het? Your choice.
Start vandaag (ja, vandaag)
Track eerst je huidige intake – hoeveel koffie drink je echt? Be honest. Kies dan je way out: cold turkey of geleidelijk (ik stem voor cold turkey, maar jij kent jezelf het beste). Zorg dat je alle support middelen in huis hebt. Set een datum en vertel het aan iemand omdat accountability matters. Plan ten slotte voor withdrawal-hell door je agenda zover mogelijk te clearen voor de eerste week – this is not the time for big meetings.
Voor extra ondersteuning tijdens je transition helpt mijn MetaPWR Advantage + Mito2Max combo voor dagelijkse energie zonder crashes, een quality sleep routine van 7-9 uur (non-negotiable!), regelmatige beweging van minimaal 30 minuten per dag, stress management door yoga of meditatie, en meer hydratie dan je denkt dat je nodig hebt.
The bottom line
Je natuurlijke energie is krachtig, zuiver en all you need voor een dag vol vitaliteit. Leer weer te genieten van de zonsondergang en het bloemetje langs de weg. Leef met al jouw zinnen vol open. Life is beautiful!
Time to live it to the fullest. 🌟
Vragen over je koffie-detox journey? Stuur me een bericht. I’ve been there, en ik help je er doorheen. Meer Lifestyle tips? Doe de GOOD. Assessment.
P.S. Yes, deze blog gaat mensen triggeren. Good. Sometimes we need uncomfortable truths to create real change. Deel dit gerust met die ene collega, die je telkens bij de koffieapparaat ziet staan.